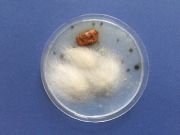
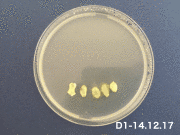

This special page shows all uploaded files.
| Date | Name | Thumbnail | Size | Description | Versions |
|---|---|---|---|---|---|
| 06:38, 10 July 2018 | No playground in Kandun.jpeg (file) |  |
711 KB | File uploaded with MsUpload | 1 |
| 06:36, 10 July 2018 | Kandun Cixi Zhejiang.jpeg (file) |  |
410 KB | File uploaded with MsUpload | 1 |
| 06:17, 10 July 2018 | Berlin Playground Information.png (file) |  |
733 KB | File uploaded with MsUpload | 1 |
| 06:17, 10 July 2018 | Berlin Playground Distribution.png (file) |  |
2.84 MB | File uploaded with MsUpload | 1 |
| 06:12, 10 July 2018 | Play with billboard.jpg (file) |  |
2.3 MB | File uploaded with MsUpload | 1 |
| 06:01, 10 July 2018 | Playground - Theaterplatz.jpeg (file) |  |
332 KB | File uploaded with MsUpload | 1 |
| 22:07, 20 April 2018 | Sinan Körper Raum Stadt.001.jpeg (file) |  |
287 KB | File uploaded with MsUpload | 1 |
| 22:07, 20 April 2018 | Sinan Körper Raum Stadt 19.001.jpeg (file) |  |
524 KB | File uploaded with MsUpload | 1 |
| 23:28, 8 April 2018 | A.jpg (file) |  |
1.69 MB | File uploaded with MsUpload | 3 |
| 23:28, 8 April 2018 | D.jpg (file) |  |
1.89 MB | File uploaded with MsUpload | 2 |
| 23:28, 8 April 2018 | C.jpg (file) |  |
1.68 MB | File uploaded with MsUpload | 3 |
| 23:28, 8 April 2018 | B.jpg (file) |  |
1.46 MB | File uploaded with MsUpload | 6 |
| 23:28, 8 April 2018 | 13th February.jpg (file) |  |
1.46 MB | File uploaded with MsUpload | 1 |
| 23:10, 8 April 2018 | 5th February.jpg (file) |  |
1.34 MB | File uploaded with MsUpload | 1 |
| 23:07, 8 April 2018 | 1st February.jpg (file) |  |
1.27 MB | File uploaded with MsUpload | 1 |
| 14:54, 31 January 2018 | Slime molds intro.jpg (file) |  |
1.45 MB | File uploaded with MsUpload | 1 |
| 14:46, 31 January 2018 | Agar2.jpg (file) |  |
296 KB | File uploaded with MsUpload | 1 |
| 14:46, 31 January 2018 | Agar1.jpg (file) |  |
315 KB | File uploaded with MsUpload | 1 |
| 14:44, 31 January 2018 | Mushroom2.jpg (file) | |
271 KB | File uploaded with MsUpload | 1 |
| 14:44, 31 January 2018 | Mushroom1.jpg (file) |  |
312 KB | File uploaded with MsUpload | 1 |
| 14:09, 31 January 2018 | Slime mold introduction.png (file) | Error creating thumbnail: File with dimensions greater than 12.5 MP |
6.38 MB | File uploaded with MsUpload | 1 |
| 15:44, 20 December 2017 | Agar in Tube 1.jpg (file) |  |
664 KB | File uploaded with MsUpload | 1 |
| 15:43, 20 December 2017 | Tube 1.jpg (file) |  |
869 KB | File uploaded with MsUpload | 1 |
| 15:42, 20 December 2017 | Test on 20.12.jpg (file) |  |
1.58 MB | File uploaded with MsUpload | 1 |
| 15:00, 20 December 2017 | Bottle.gif (file) |  |
11.39 MB | File uploaded with MsUpload | 1 |
| 14:42, 20 December 2017 | No-face-14.12-20.12.gif (file) | |
7.98 MB | File uploaded with MsUpload | 2 |
| 14:23, 20 December 2017 | Face-14.12-20.12.gif (file) |  |
8.28 MB | File uploaded with MsUpload | 1 |
| 00:01, 15 December 2017 | Idea.jpeg (file) | 235 KB | File uploaded with MsUpload | 1 | |
| 23:05, 14 December 2017 | No face 21.30.jpeg (file) |  |
1.6 MB | File uploaded with MsUpload | 1 |
| 23:05, 14 December 2017 | Face 21.30.jpeg (file) |  |
1.75 MB | File uploaded with MsUpload | 1 |
| 23:00, 14 December 2017 | No face 21.5.jpeg (file) |  |
1.6 MB | File uploaded with MsUpload | 1 |
| 23:00, 14 December 2017 | Face 21.5.jpeg (file) |  |
1.75 MB | File uploaded with MsUpload | 1 |
| 22:56, 14 December 2017 | No face 12.JPG (file) |  |
1.9 MB | File uploaded with MsUpload | 1 |
| 22:55, 14 December 2017 | Face 12.JPG (file) |  |
2.26 MB | File uploaded with MsUpload | 1 |
| 22:51, 14 December 2017 | No face.JPG (file) |  |
666 KB | File uploaded with MsUpload | 1 |
| 22:51, 14 December 2017 | Face.JPG (file) |  |
1.38 MB | File uploaded with MsUpload | 1 |
| 22:51, 14 December 2017 | 3 different dishes.JPG (file) |  |
1.33 MB | File uploaded with MsUpload | 1 |
| 22:40, 14 December 2017 | No face 21-30.jpeg (file) |  |
1.6 MB | File uploaded with MsUpload | 1 |
| 22:40, 14 December 2017 | Face 21-30.jpeg (file) |  |
1.75 MB | File uploaded with MsUpload | 1 |
| 22:39, 14 December 2017 | No face 12pm.JPG (file) |  |
1.9 MB | File uploaded with MsUpload | 1 |
| 22:39, 14 December 2017 | Face 12pm.JPG (file) |  |
2.26 MB | File uploaded with MsUpload | 1 |
| 22:20, 14 December 2017 | Small trees.jpg (file) |  |
249 KB | File uploaded with MsUpload | 1 |
| 22:20, 14 December 2017 | Trees.jpg (file) |  |
553 KB | File uploaded with MsUpload | 1 |
| 22:17, 14 December 2017 | Grew in circle dish.jpg (file) |  |
663 KB | File uploaded with MsUpload | 1 |
| 22:16, 14 December 2017 | Grew in cube dish.jpg (file) |  |
564 KB | File uploaded with MsUpload | 1 |
| 22:01, 14 December 2017 | Fed in circle shape.jpg (file) |  |
702 KB | File uploaded with MsUpload | 1 |
| 22:00, 14 December 2017 | Fed in cube shape.jpg (file) |  |
814 KB | File uploaded with MsUpload | 2 |
| 21:56, 14 December 2017 | Fed in circle shape.jpeg (file) |  |
702 KB | File uploaded with MsUpload | 1 |
| 21:56, 14 December 2017 | Fed in cube shape.jpeg (file) |  |
814 KB | File uploaded with MsUpload | 1 |